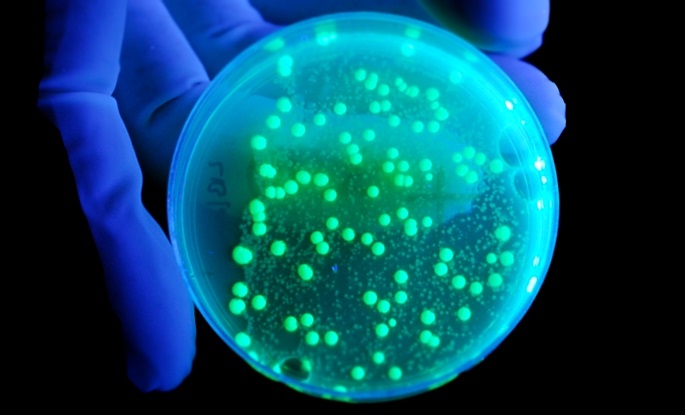
Hastalık X: DSÖ, Gelecekteki Salgının Sadece Bir Zaman Meselesi Olduğu Uyarısında Bulundu

Hastalık X: DSÖ, Gelecekteki Salgının Sadece Bir Zaman Meselesi Olduğu Uyarısında Bulundu.
Ölüm oranı COVID-19’un 20 katı olan ve henüz aşısı bulunmayan X Hastalığı, insanlığı hızla zor duruma düşürebilir. Patojen etkisini göstermeye başladığında, çok az kişi bundan etkilenmeyecek ve dünya bir kez daha doğanın kontrol altına alınmaya çalışıldığı bir durumla karşı karşıya kalacaktır, bu da sağlık sistemlerinin çökmesine ve ekonomilerin çökmesine neden olabilir.
Neyse ki, Hastalık X varsayımsaldır – henüz karşılaşılmamış patojenleri temsil eden bir yer tutucudur.
Ancak, Dünya Sağlık Örgütü (DSÖ), İsviçre’nin Davos kentinde düzenlenen Dünya Ekonomik Forumu’nun son yıllık toplantısında, dünya liderlerinden böyle bir senaryonun ürkütücü olasılığını göz önünde bulundurmalarını isteme fırsatını yakaladı.
DSÖ’ye üye kuruluşlar, 2015 yılında uluslararası toplumun önemli hastalık salgınlarına karşı aşırı hazırlıksız olduğunu fark etmiş ve Salgınları Önlemek için Ar-Ge Eylem Planı adı verilen bir planı kısa süre içinde başlatmıştı. Bu plan, endişe verici nedenlerle patojenleri listeliyor.
Şubat 2018’de yapılan bir toplantının ardından komite, potansiyel katiller listesine boş bir kutu ekledi: Komitenin amacı, yetkilileri hazırlıklarında esnek olmaya ve bilinen hastalıklarla ilgili bilgilerle kısıtlanmamaya zorlamaktı.
İki yıl sonra, yeni bir koronavirüs türünün hızla yayılması tüm pandemi planlarını teste tabi tutacaktı. Sonuç, 7 milyondan fazla ölüm, yavaş önlemler ve hızlı aşı geliştirmenin bir uzlaşması oldu – bu sayı aynı anda hem çok daha iyi hem de çok daha kötü olabilirdi.
Öncelikli patojenler listesi, COVID-19 şiddetlenirken bile yeniden gözden geçirildi ve yüzlerce bilim insanı 2022’de bir araya gelerek bilinen 25 mikrobik aileye ilişkin kanıtları değerlendirdi ve gelecekteki bir salgının ne gibi tehditler oluşturabileceği üzerine spekülasyonlar yaptı.
Dünya çapında bir dizi devletten temsilcilerle yapılan bir dizi istişarede DSÖ, şu anda hakkında hiçbir şey bilmediğimiz bir patojenin önlenmesinde karşılaşılan keşif, gözetim, araştırma ve sosyopolitik zorlukları ele aldı.
DSÖ Genel Direktörü Tedros Adhanom Ghebreyesus, örgütün bir pandemi fonu kurulması ve aşı dağıtımındaki eşitsizlikleri gidermek için Güney Afrika’da bir teknoloji transfer merkezi kurulması gibi önlemleri halihazırda uygulamaya koyduğunu belirtti.
Tedros panele “Elbette bunun panik yaratabileceğini söyleyenler var,” dedi.
“Olabilecek bir şeyi öngörmek daha iyidir çünkü tarihimizde birçok kez olmuştur ve buna hazırlanmak gerekir.”
Kendi davranışlarımıza bakmak, bir patojenin tehditlerini öngörmede patojenin kendisini anlamak kadar aydınlatıcıdır.
Belki de COVID-19’dan çıkarılan en derin derslerden biri, yanlış bilgilendirme ve komplo korkusunun yarattığı zorluklardır.
ABD Hazine Bakanlığı’nın Halkla İlişkilerden Sorumlu eski Güvenlik Yardımcısı Monica Crowley, siyasi muhalefeti örneklendirircesine, X (eski adıyla Twitter) üzerinden şunları söyledi: “Tam da seçim zamanında, yeni bir DSÖ anlaşması uygulamalarına, yeniden kilitlenmelerine, ifade özgürlüğünü kısıtlamalarına ve daha fazla özgürlüğü yok etmelerine olanak tanıyacak yeni bir bulaşıcı hastalık.”
COVID-19’a eşit veya daha kötü bir pandemiyi yönetmek, yanlış bilgilendirmeye karşı korunmak için etkili kamu iletişim stratejileri geliştirmek, potansiyel karantinalarla başa çıkmak için ekonomik ve ruh sağlığı planlarını güçlendirmek ve eğitim sistemlerine daha fazla esneklik kazandırmak anlamına gelecektir.
Hazırlanmak için X Hastalığı hakkında çok şey bilmemize gerek yok. Bilmemiz gereken tek şey, toplumumuzu zarardan korumak anlamına geldiğinde büyük başarılar elde edebileceğimizdir.
Derleyen: Deniz KAFKAS
Kaynak: Hastalık X: DSÖ, Gelecekteki Salgının Sadece Bir Zaman Meselesi Olduğu Uyarısında Bulundu